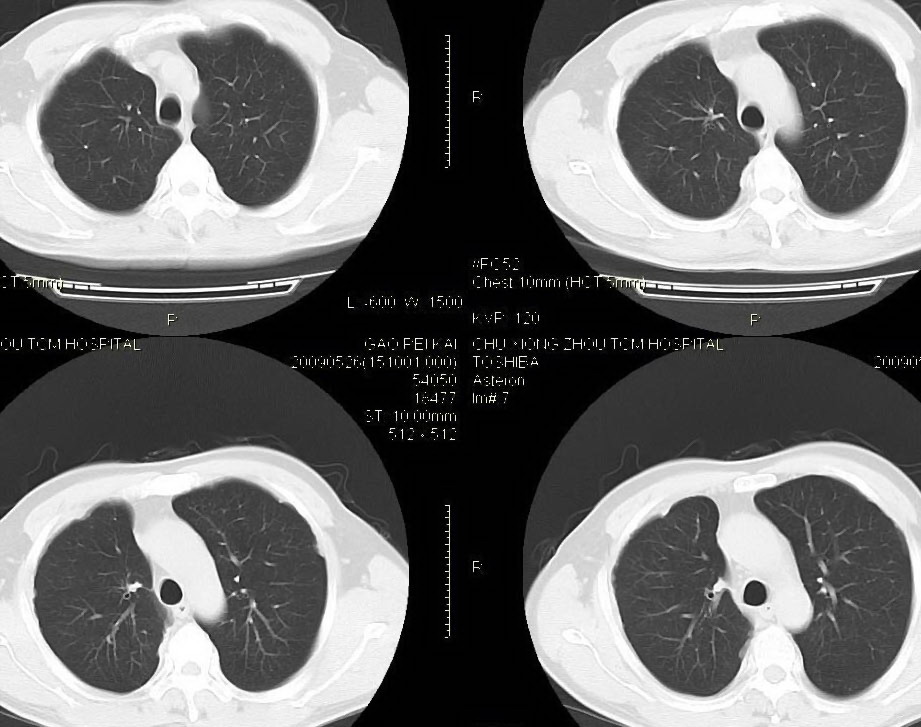

医影在线
标题: CT20208:男,56岁,右侧腋窝下巨大软组织包块转移。欢迎讨 [打印本页]
作者: zjh196425 时间: 2009-5-27 21:39
标题: CT20208:男,56岁,右侧腋窝下巨大软组织包块转移。欢迎讨
男,56岁,右侧腋窝下巨大软组织包块转移。欢迎讨论。

该病例为已经确诊的右侧恶性胸膜间皮瘤病例,有青石棉接触史,早期就是胸水,右侧胸壁“花边状改变”,心隔角区软组织阴影形成。近期右侧腋窝下巨大软组织包块,病检为转移瘤。图片没有完全考来,主要是给大家看一下胸膜间皮瘤的病例。,右侧
有关胸膜间皮瘤的讨论可以参见典型病例栏目cl1000图片及文字的讨论。
右侧腋窝下巨大软组织包块已经被切除后的ct片,该病例有多家医院较多的ct检查片。
[本贴已被 zjh196425 于 2009-6-8 14:07:19 修改过]
作者: 深泽交通 时间: 2009-5-27 22:21
考虑站位并肺不张
作者: zsl6918 时间: 2009-5-27 22:25
并未见楼主所说的巨大占位.
作者: bmw011 时间: 2009-5-27 22:36
右肺下叶节段性肺不张、右侧胸膜肥厚并包裹性积液。“右侧腋窝下巨大软组织包块转移?”就目前图片看,没见!请上传完整图像。
作者: 随光逐影 时间: 2009-5-27 23:14
1)右肺中叶节段性肺不张。2)右肺中叶肺癌不排除。3)右侧胸膜增厚。
作者: LIAOQIANG 时间: 2009-5-28 00:04
右心膈角区一不规则肿块伴相邻胸膜不规则增厚,考虑胸膜间皮瘤(恶性)?右肺中叶内侧段肺癌?建议穿刺活检。
作者: zjzjr 时间: 2009-5-28 00:23
1)右肺中叶节段性肺不张。2)右肺中叶肺癌不排除。3)右侧胸膜增厚。
作者: hguox 时间: 2009-5-28 01:26
1)右肺中叶节段性肺不张。2)右肺中叶肺癌不排除。3)右侧胸膜增厚。
作者: ct诊断高手 时间: 2009-5-28 02:01
结合病史 考虑右侧中央型肺癌可能!
作者: 宇宙CT 时间: 2009-5-28 02:06
右肺下叶节段性肺不张、右侧胸膜肥厚并包裹性积液。“右侧腋窝下巨大软组织包块转移?”就目前图片看,没见!请上传完整图像。
作者: zbp537 时间: 2009-5-28 05:28
1、右肺中叶肺不张,建议纤支镜进一步检查。
2、右侧胸膜增厚。
作者: 黑白光影 时间: 2009-5-28 05:41
1)右肺中叶节段性肺不张。2)右肺中叶肺癌不排除。3)右侧胸膜增厚。
作者: qiuleiyu 时间: 2009-5-28 05:46
支持;1、右肺中叶肺不张,建议纤支镜进一步检查。
2、右侧胸膜增厚。
作者: pujunzhi 时间: 2009-5-28 20:23
标题: 回复:ct20208:男,56岁,右侧腋窝下巨大软组织包块转移。
以下是引用随光逐影在2009-5-27 15:14:00的发言:[br]1)右肺中叶节段性肺不张。2)右肺中叶肺癌不排除。3)右侧胸膜增厚。
作者: fyanj168 时间: 2009-5-28 21:02
右肺中叶节段性肺不张
| 欢迎光临 医影在线 (http://bbs.radida.com/bbs/) |
Powered by Discuz! X3.2 |